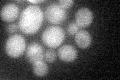
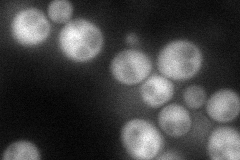
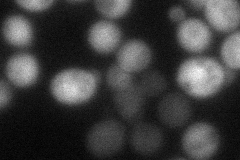

View description
Beta subunit of geranylgeranyltransferase type I, catalyzes geranylgeranylation to the cysteine residue in proteins containing a C-terminal CaaX sequence ending in Leu or Phe; has substrates important for morphogenesis
Localization:
Intensity:
Fold change:
Significance:
-
C’ GFP library in SD
cytosol22.8 -
N' NOP1pr-GFP in SD
cytosol68.7743 -
N' TEF2pr-mCherry in SD
cytosol48.8165 -
N' NATIVEpr-GFP in SD

below threshold22.6643 -
N' TEF2pr-VC and Cyto-VN in SD

#N/A0 -
C’ GFP library in SD+DTT

cytosol19.220.84No -
C’ GFP library in SD+H2O2

cytosol25.171.1No -
C’ GFP library in Starvation Media

cytosol36.581.6No -
C’ GFP library on the background of Pup2-DaMP

cytosol -
C’ GFP library on the background of CCT mutant

cytosol23.08881.01237No
